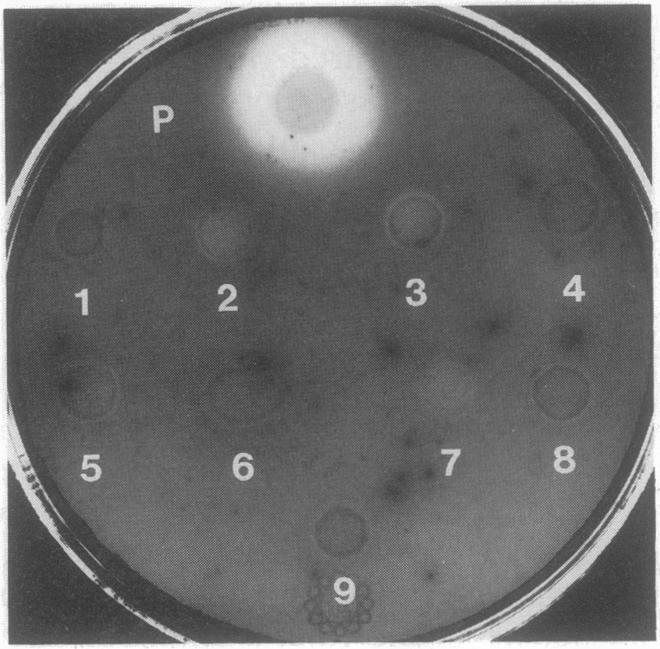
https://cdn.ncbi.nlm.nih.gov/pmc/blobs/bebf/193031/11e4548d96e9/jbacter00046-0238-a.jpg

支气管败血波氏杆菌铁载体活性缺陷突变体的分离与鉴定
Isolation and characterization of Bordetella bronchiseptica mutants deficient in siderophore activity.
作者信息
Armstrong S K, Clements M O
机构信息
Department of Microbiology and Immunology, East Carolina University School of Medicine, Greenville, North Carolina 27858-4354.
出版信息
J Bacteriol. 1993 Feb;175(4):1144-52. doi: 10.1128/jb.175.4.1144-1152.1993.
Iron acquisition by the gram-negative pathogens Bordetella bronchiseptica and Bordetella pertussis is thought to occur by hydroxamate siderophore-mediated transport as well as an apparently siderophore-independent process by which host transferrins bind to bacterial surface receptors. We constructed B. bronchiseptica mutants deficient in siderophore activity by insertional mutagenesis with miniTn5/lacZ1. The mutants could be placed into four distinct complementation groups, as determined from cross-feeding assays which demonstrated restored siderophore synthesis. Mutants deficient in siderophore activity were BRM1, BRM6, and BRM9, exhibiting approximately 36 to 41% of wild-type siderophore levels, and BRM3 and BRM8, which appeared to produce very little or no detectable siderophore. Mutant BRM4 was found to be a leucine auxotroph, while mutants BRM2 and BRM7 could synthesize siderophore only in low-iron medium which was supplemented with various amino acids. Evaluation of all transcriptional fusions revealed an apparent lack of iron-regulated lacZ expression. Genomic regions flanking the transposable element in the siderophore mutants were homologous with B. pertussis chromosomal DNA, while bioassays suggested siderophore cross-feeding between B. pertussis and B. bronchiseptica. These results indicate probable similarity between the siderophore biosynthetic and transport systems of the two species.
革兰氏阴性病原菌支气管败血博德特氏菌和百日咳博德特氏菌获取铁的方式,被认为是通过异羟肟酸铁载体介导的转运,以及一个明显不依赖铁载体的过程,即宿主转铁蛋白与细菌表面受体结合。我们通过用miniTn5/lacZ1进行插入诱变,构建了铁载体活性缺陷的支气管败血博德特氏菌突变体。根据交叉补料试验确定突变体可分为四个不同的互补组,该试验证明了铁载体合成得以恢复。铁载体活性缺陷的突变体有BRM1、BRM6和BRM9,其铁载体水平约为野生型的36%至41%,还有BRM3和BRM8,它们似乎产生很少或无法检测到的铁载体。发现突变体BRM4是亮氨酸营养缺陷型,而突变体BRM2和BRM7仅在添加了各种氨基酸的低铁培养基中才能合成铁载体。对所有转录融合体的评估显示,明显缺乏铁调节的lacZ表达。铁载体突变体中转座元件两侧的基因组区域与百日咳博德特氏菌染色体DNA同源,而生物测定表明百日咳博德特氏菌和支气管败血博德特氏菌之间存在铁载体交叉补料。这些结果表明这两个物种的铁载体生物合成和转运系统可能具有相似性。